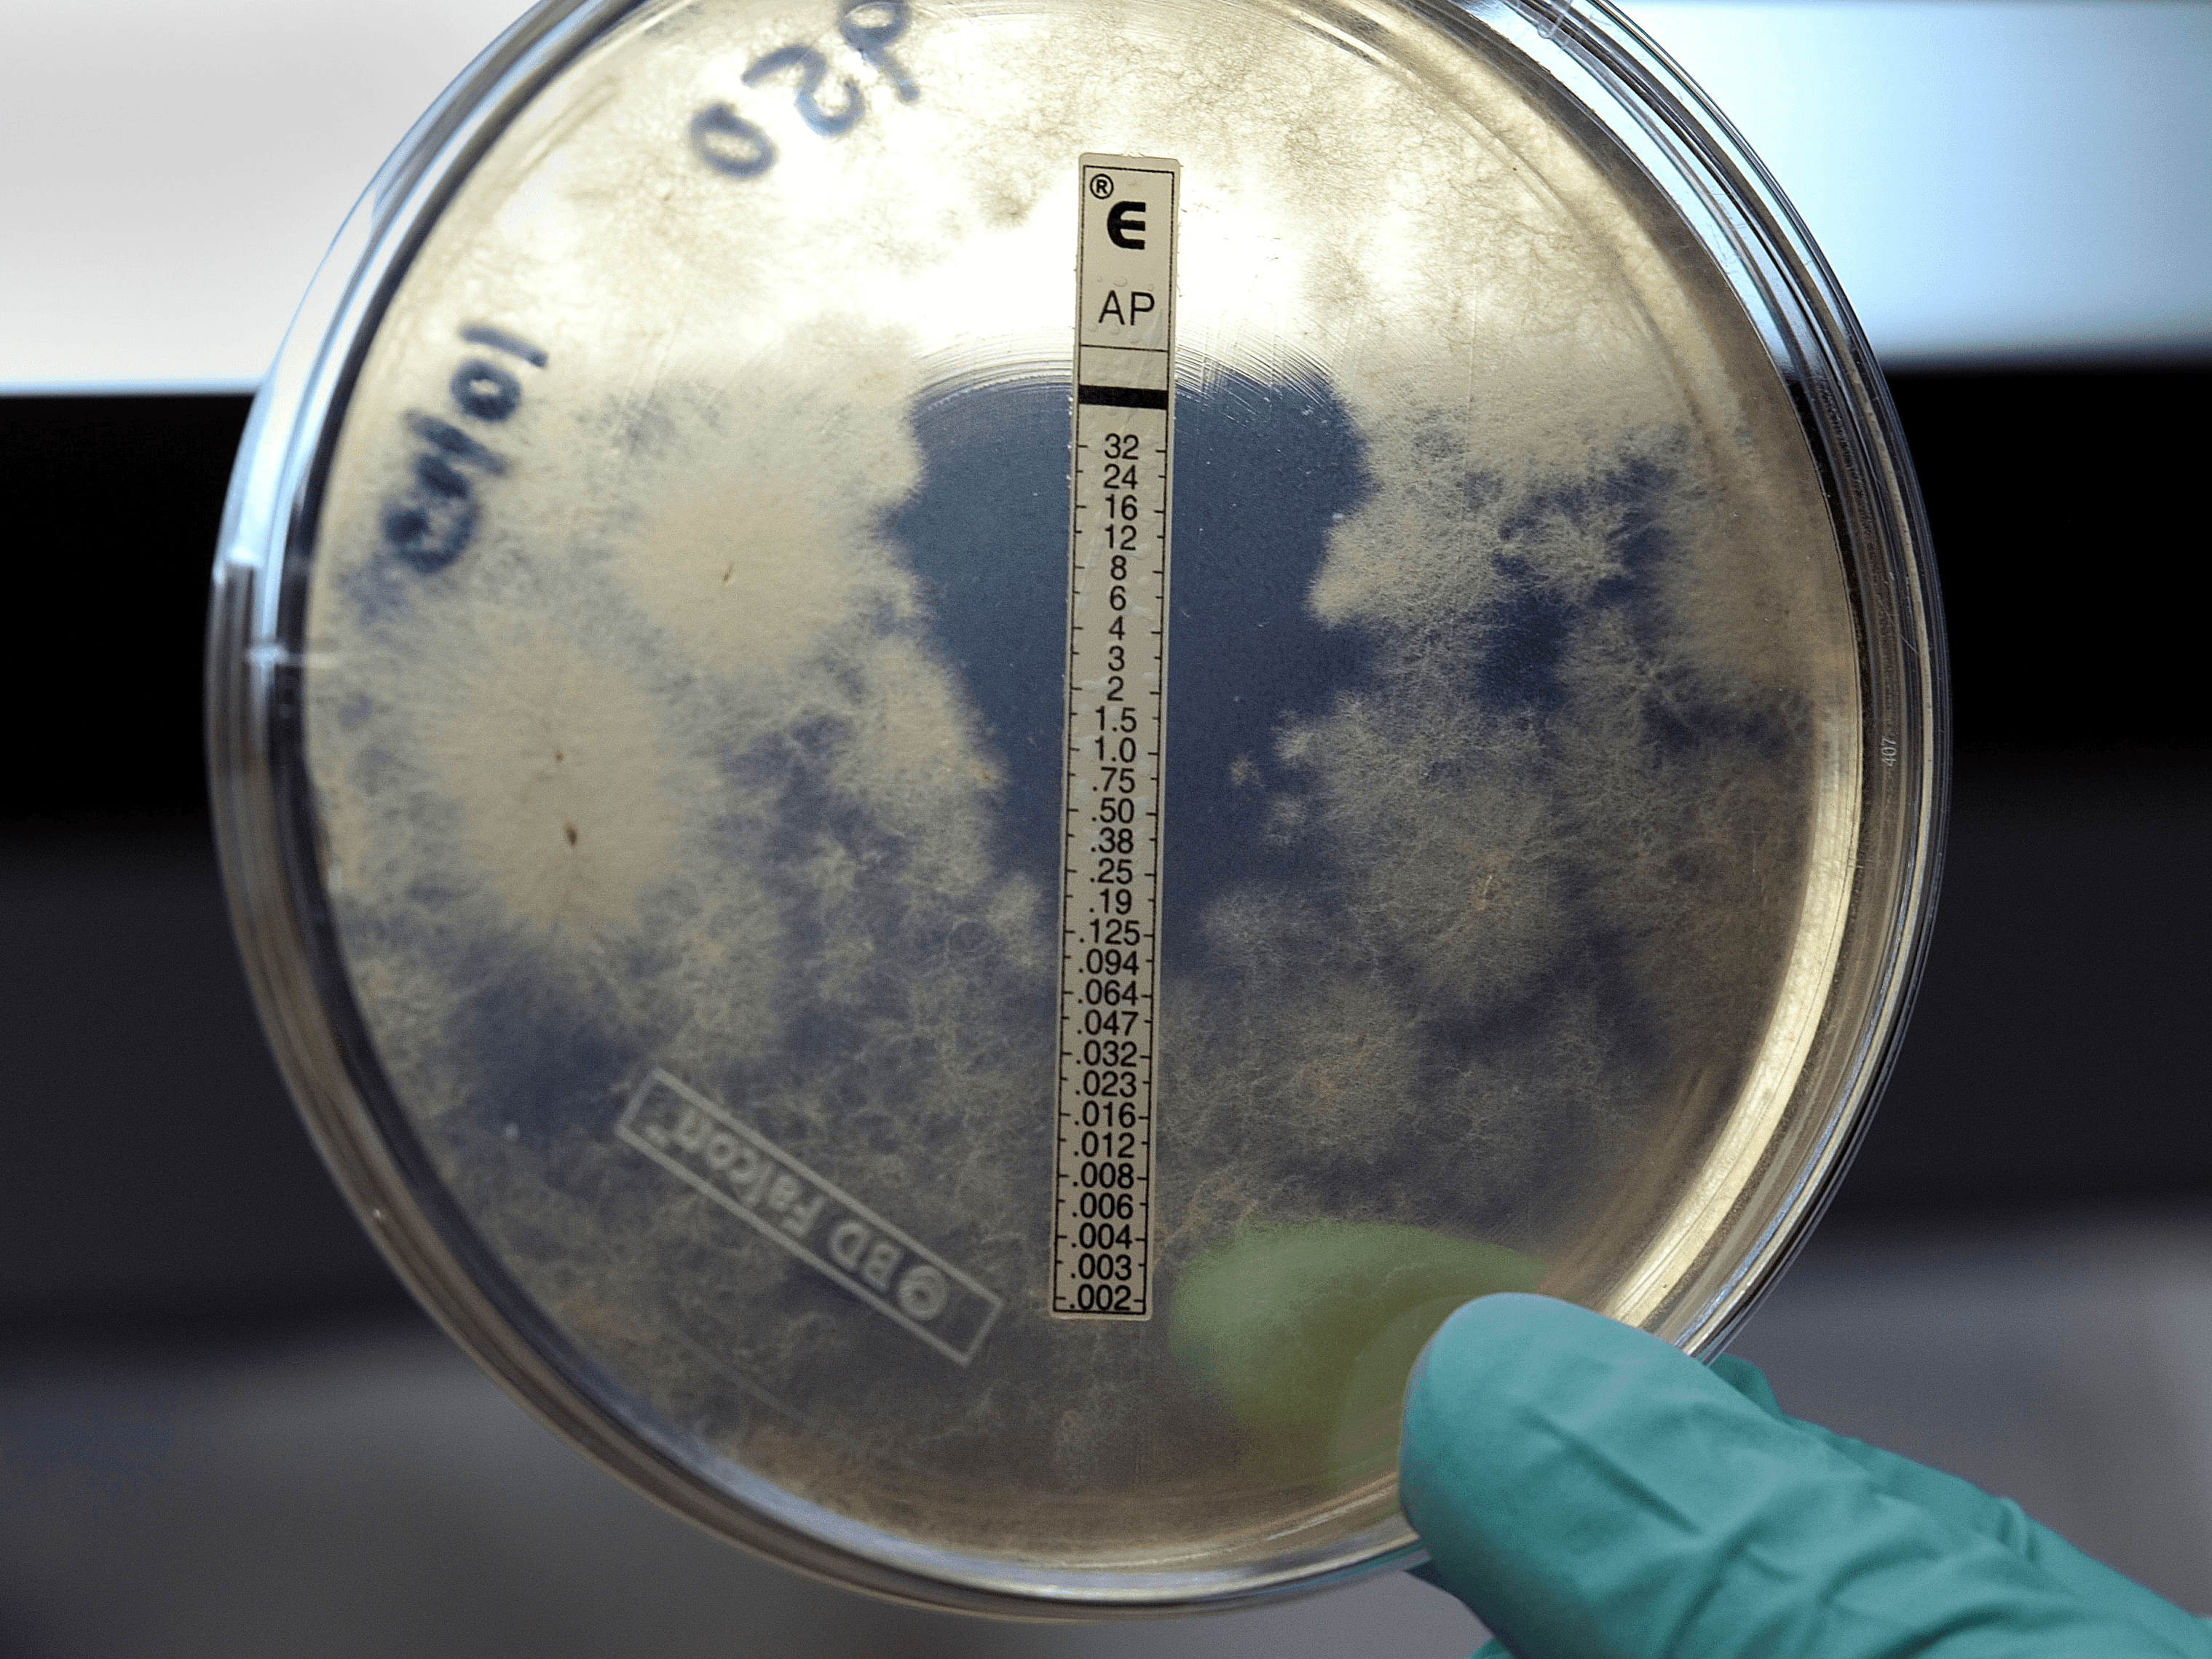
F2G announce development and commercialisation for rare antifungal treatment

49 articles from this collection:

Monkeypox antiviral tecovirimat put to the test
The antiviral was developed to treat poxviruses

First disease-modifying treatment for AADC deficiency
The EC has approved the first gene therapy directly infused into the brain

FlyPharma Conference Europe

Future Focus

COMMUNIQUE

Contents

Words from the Editor
Hi readers, Welcome to the September 2022 issue of Pharmafocus!

SAMEDAN

MPs warn NHS England facing worst staffing crisis in history
17,000 care workers paid below minimum wage of £9.50 an hour in England

Potential shortage of 140,000 nurses in NHS England by 2030
Leading nurses describe the projected numbers as “apocalyptic”

£70 million in fines for pharma firms that overcharged NHS
The CMA has found that Pfizer and Flynn charged unfairly high prices for phenytoin sodium capsules for over four years, which were ultimately paid for by the NHS.

UK scientists say they have found cancer driver in junk DNA
The study suggests that junk DNA is potentially destructive to cells

New reforms aim for better NHS dental service access
NICE guidance recommends patients should recieve oral checkup based on health risk

EMA Round-up
EMA responds to monkeypox public health emergency, EMA recommends treatment for multiple myeloma patients with limited options

NICE issues positive appraisal for advanced kidney cancer treatment
Lenvatinib is indicated or treatment for adults with advanced renal cell carcinoma

Medics in Ukraine work amid shelling and worsening health crisis
Ukraine’s health emergency is worsening, WHO have shared as the conflict with Russia continues, and staff face burnout and increased shelling. So far, there have been 434 attacks on healthcare facilities in the country.

Monkeypox declared global health emergency
The move marks the seventh declared global health emergency since 2009

Global monkeypox cases rise to 26,000
Between five and 10 million vaccine doses needed to protect high-risk groups

FDA Round-up
FDA approval for neurostimulation device to treat diabetic neuropathic pain, FDA approves new treatment for rare tumour

HealthTrackRx develops monkeypox specific PCR test with next-day results
HealthTrackRx is now offering a molecular test for detection of the human monkeypox virus.

Micronesia’s first COVID-19 outbreak sees steep rise in cases
Micronesia’s first outbreak of COVID-19 has grown in one week to over 1,000 cases, causing significant alarm in the Pacific Island nation.

Recent hepatitis linked to adeno-associated virus AAV2
Recent acute hepatitis cases of unknown origin in children have now been linked to the virus AAV2 in two new UK studies, with no evidence of a direct link to SARS-CoV-2 infection.

Initiative to improve next generation cancer diagnostics
The Medical Device Innovation Consortium (MDIC) has formally launched its Somatic Reference Samples (SRS) Initiative with a pilot project.

Home-based brain stimulation study on stroke survivors finds mixed results
26 stroke survivors were given four weeks of remotely supervised transcranial direct current stimulation (RS-tDCS) in an at-home cognitive rehabilitation pilot study, which revealed this method to be feasible, but not wholly effective.

New method involving musical tests can enable early detection of cognitive decline
Researchers at Tel Aviv University have created a method which uses musical tests and a portable brain activity-measuring device to detect cognitive decline in older people.

MiroBio to be acquired by Gilead Sciences
This partnership will accelerate MiroBio’s candidates into treatments for patients

US government buys 66 million doses of Moderna’s Omicron booster
The US government has confirmed its plans to begin a booster vaccination campaign this autumn, and has placed a $1.74 billion order for 66 million doses of an updated version of Moderna’s Spikevax shot.

Sanofi makes €300 million investment in Innovent for cancer
Sanofi has announced a €300 million investment in Chinese biotech Innovent, as part of a collaboration to bring two new cancer therapies as quickly as possible to patients.

PCI Pharma Services announces multi-million dollar expansion to UK manufacturing facility
PCI has announced a significant expansion of its facility in Tredegar in Wales, UK, designed to help keep up to date with the market growth of powerful, targeted oncology therapies.

CDMO wins tech transfer and production contract for HIV drug candidate
Societal CDMO, a contract development and manufacturing organisation (CDMO), has been selected to provide CDMO services to support the ongoing clinical development of a novel HIV drug candidate in Europe.
F2G announce development and commercialisation for rare antifungal treatment
F2G, a clinical-stage biopharmaceutical company, has announced that it can now bring a fourth antifungal class to the market. Currently, there are only three classes of antifungal treatments.

Cognito’s light-and-sound therapy slows brain tissue atrophy in Alzheimer’s study
The company plans to launch new trials into Alzheimer's disease this year

Digital physical therapy app OneStep launches fall risk detection using a smartphone
OneStep, an app-based physical therapy service, has expanded its technology to include fall risk detection capabilities.

ResMed buys Mementor for prescription digital health app
ResMed has acquired Mementor to add an insomnia digital health application to its portfolio of products in Germany.

Personalised healthcare is key to a sustainable NHS – and pharma can help
Doina Ionescu, General Manager at Merck, UK & Ireland, explores the importance of personalised healthcare and supported self-management, and highlights the work that Merck is doing in these areas

Up close and personal: The potential of precision medicine in mental health
Personalised medicine has revolutionised treatments and kept patients at the fore, across an array of therapeutic areas. Lina Adams illuminates the applications that this has, and is continuing to have, in the field of mental healthcare

Pharmatimes

Access all areas: increasing health equity with early access
Time is an invaluable resource in healthcare, and bringing life saving therapies to the patient is paramount. Ana Ovey explores the importance of early access to medicine schemes in deploying treatments to the patients who need it, and other areas this programme can be applied.

10 steps closer to the patient – The pharma industry post-COVID-19
Emma Banks, CEO, Ramarketing, delves into the connection between patients and the companies in the pharmaceutical supply chain, and shares how this relationship was strengthened by the pandemic

The evolving landscape of RA treatments
Professor Rieke Alten, Head of the Department of Internal Medicine at Schlosspark-Klinik, illuminates the benefits of subcutaneous infliximab in treating rheumatoid arthritis

Immunisation or hospitalisation: what RWE tells us about vaccines
Pharmafocus sat down with Joaquin Mould, Global HEOR & Value Strategy Director, Seqirus, to get to the heart of what invaluable insights RWE can give us on vaccine efficacy

Ergomed

FlyPharma Conference Europe

Janssen promoted Maria Walsh to Business Unit Director
Janssen has announced the appointment of Maria Walsh as Business Unit Director, Oncology & Haemotology, Cell & Gene Therapy and Pulmonary Hypertension for Janssen UK.

COMPASS Pathways appoints Kabir Nath as CEO
COMPASS Pathways has announced the appointment of Kabir Nath as CEO as of 1 August. Kabir brings decades of experience in the healthcare industry into his new role.

Chris Tower joins Euromed USA as new general manager
Chris is a highly experienced, senior level executive, with an extensive range of skills and over 25 years of successful sales, business development, and operations expertise in the US.

Pmlive

5 examples of personalised medicine
Personalised medicine is a type of medical treatment customised for an individual patient. In this section, we explore how this has been applied across numerous therapeutic areas.

Samedan
